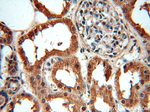
MAT2B Antibody in Immunohistochemistry (Paraffin) (IHC (P))

Search
Proteintech
MAT2B Polyclonal Antibody
{{$productOrderCtrl.translations['antibody.pdp.commerceCard.promotion.promotions']}}
{{$productOrderCtrl.translations['antibody.pdp.commerceCard.promotion.viewpromo']}}
{{$productOrderCtrl.translations['antibody.pdp.commerceCard.promotion.promocode']}}: {{promo.promoCode}} {{promo.promoTitle}} {{promo.promoDescription}}. {{$productOrderCtrl.translations['antibody.pdp.commerceCard.promotion.learnmore']}}
产品信息
15952-1-AP
种属反应
已发表种属
宿主/亚型
分类
类型
抗原
偶联物
形式
浓度
规格
纯化类型
保存液
内含物
保存条件
运输条件
产品详细信息
Immunogen sequence: MPEMPEDME QEEVNIPNRR VLVTGATGLL GRAVHKEFQQ NNWHAVGCGF RRARPKFEQV NLLDSNAVHH IIHDFQPHVI VHCAAERRPD VVENQPDAAS QLNVDASGNL AKEAAAVGAF LIYISSDYVF DGTNPPYREE DIPAPLNLYG KTKLDGEKAV LENNLGAAVL RIPILYGEVE KLEESAVTVM FDKVQFSNKS ANMDHWQQRF PTHVKDVATV CRQLAEKRML DPSIKGTFHW SGNEQMTKYE MACAIADAFN LPSSHLRPIT DSPVLGAQRP RNTQLDCSKL ETLGIGQRTP FRIGIKESLW PFLIDKRWRQ TVFH (1-323 aa encoded by BC005218)
靶标信息
MAT2B belongs to the methionine adenosyltransferase (MAT) family. MAT catalyzes the biosynthesis of S-adenosylmethionine from methionine and ATP. This protein is the regulatory beta subunit of MAT. Alternative splicing occurs at this locus and two transcript variants encoding distinct isoforms have been identified.
仅用于科研。不用于诊断过程。未经明确授权不得转售。
生物信息学
蛋白别名: beta regulatory subunit of methionine adenosyltransferase; dTDP-4-keto-6-deoxy-D-glucose 4-reductase; MAT II beta; MAT II beta subunit; methionine adenosyltransferase 2 beta subunit; Methionine adenosyltransferase 2 subunit beta; methionine adenosyltransferase 2B; methionine adenosyltransferase complex; Methionine adenosyltransferase II beta; methionine adenosyltransferase II, beta; Putative dTDP-4-keto-6-deoxy-D-glucose 4-reductase; putative protein product of Nbla02999; short chain dehydrogenase/reductase family 23E, member 1; testicular tissue protein Li 118; unnamed protein product
基因别名: 1110064C04Rik; 2410018D16Rik; AI182287; AU022853; MAT-II; MAT2B; MATIIbeta; MSTP045; Nbla02999; SDR23E1; TGR; UNQ2435/PRO4995
UniProt ID: (Human) Q9NZL9, (Mouse) Q99LB6, (Rat) Q5U2R0
Entrez Gene ID: (Human) 27430, (Mouse) 108645, (Rat) 683630